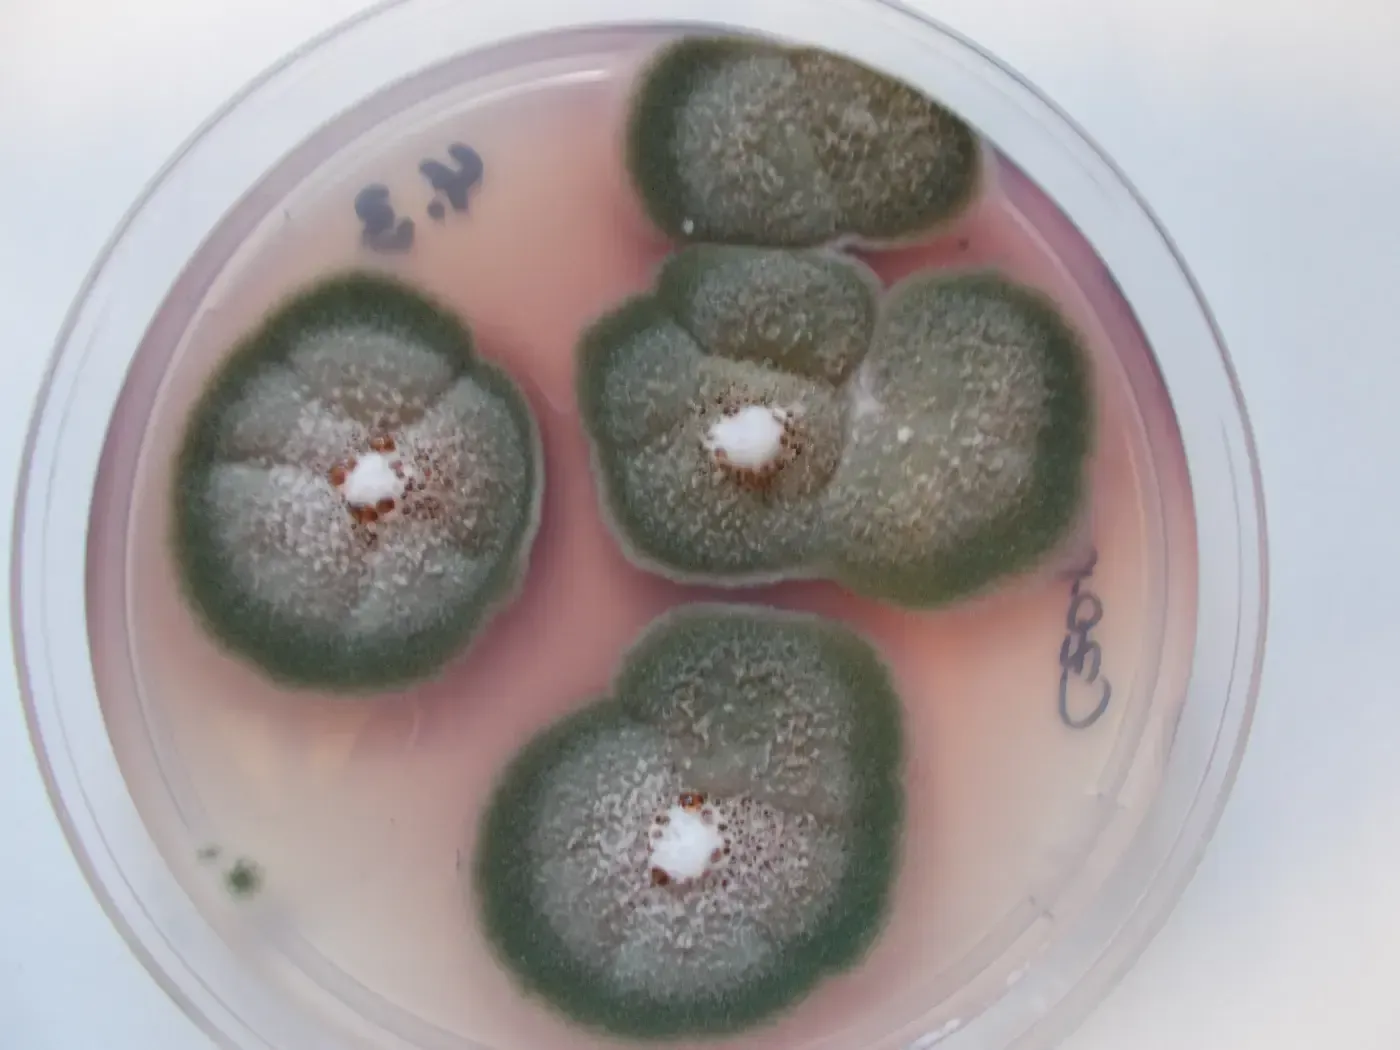
Petrischale mit vier grünen Schimmelpilzkolonien, die auf rosa Agar wachsen
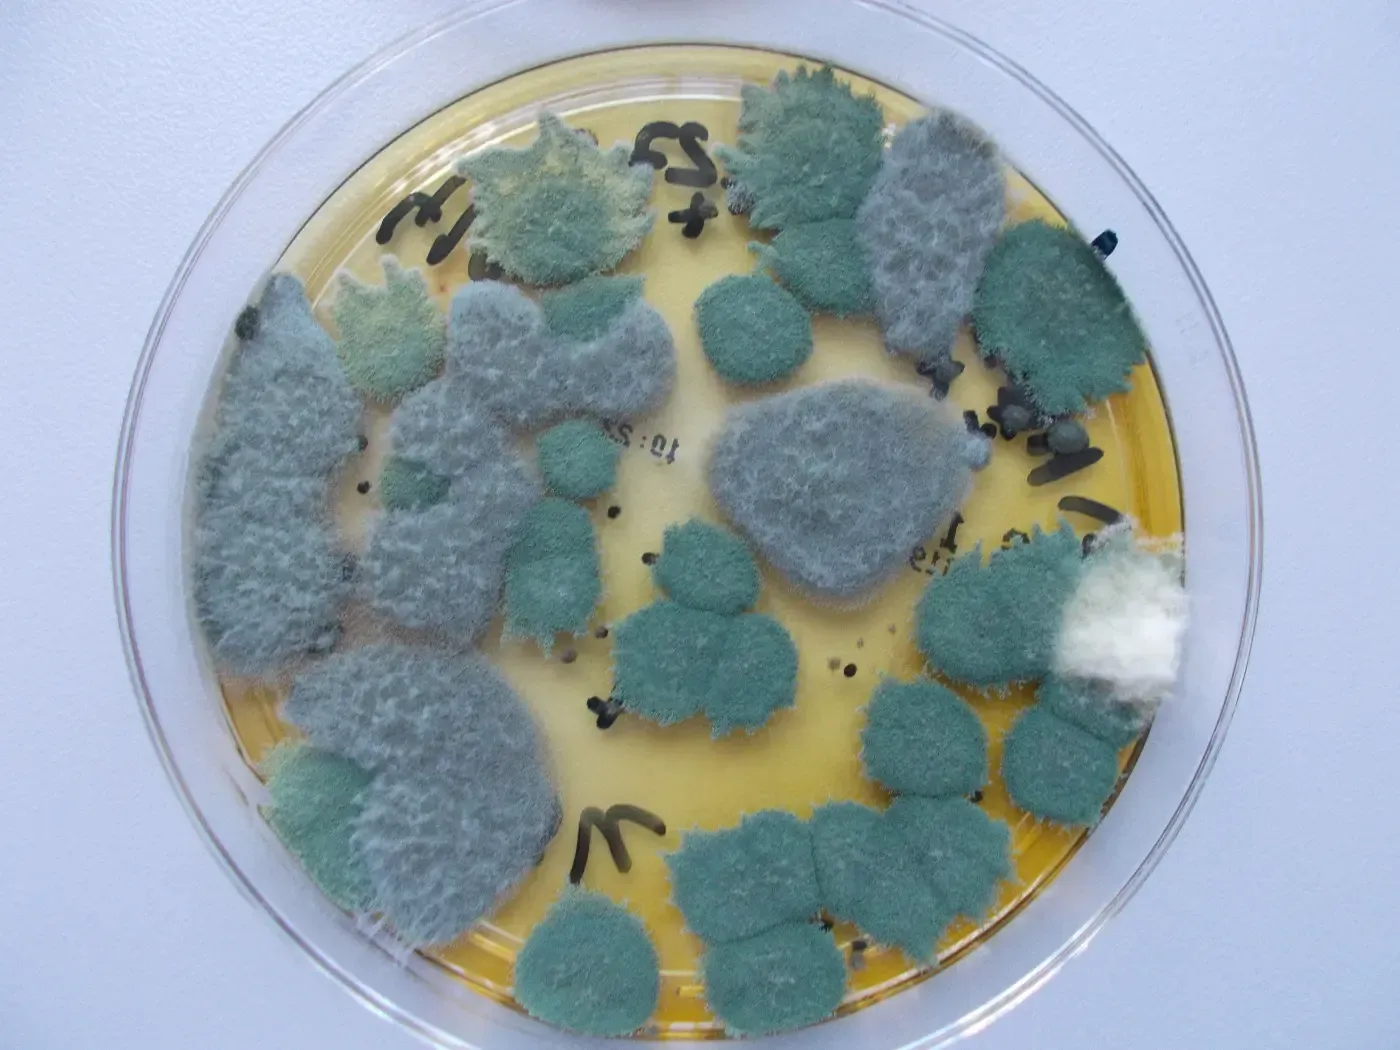
Petrischale mit blaugrünen Schimmelpilzkolonien, die auf gelbem Agar wachsen

Schimmelpilzanalysen und Schimmeluntersuchungen
Ursachen erkennen und gesundheitliche Risiken bewerten
Schimmelpilze in Innenräumen sind nicht nur ein optisches Problem, sondern können auch gesundheitliche Beschwerden verursachen. Mit einer gezielten Untersuchung lassen sich Ursachen und Belastungen zuverlässig feststellen. Die LWU Lebensmittel-, Wasser- und Umwelthygiene GmbH führt mikroskopische Schimmelpilzanalysen durch und weist Schimmelpilze auf Materialien wie Tapeten oder anderen Oberflächen nach. Wir unterstützen Sie dabei, die Situation fachgerecht zu bewerten und die richtigen Maßnahmen abzuleiten.

Analyse und Bewertung von Schimmelpilzen
Wir untersuchen Schimmelbefall in Innenräumen und liefern Ihnen eine fundierte Grundlage zur Bewertung der Situation und möglicher Maßnahmen.
Mikroskopische Schimmelpilzanalyse
Wir identifizieren Schimmelpilze auf Materialien und Oberflächen und bestimmen diese auf Gattungsebene.
Untersuchung verdächtiger Stellen
Proben werden gezielt an betroffenen Bereichen wie Wänden, Tapeten oder anderen Materialien entnommen.
Bewertung der Belastungssituation
Wir analysieren die Ergebnisse und helfen bei der Einschätzung möglicher gesundheitlicher Risiken.
Mögliche gesundheitliche Auswirkungen von Schimmel
Schimmelpilze können verschiedene Beschwerden verursachen, darunter Atemwegserkrankungen, Hautreizungen oder allergische Reaktionen. Einige Arten bilden zudem Stoffwechselprodukte, die gesundheitlich belastend sein können. Die Auswirkungen sind individuell unterschiedlich und hängen von der Art und Intensität des Befalls ab. Eine fachgerechte Analyse hilft, mögliche Risiken besser einzuschätzen.

So entsteht Schimmel in Innenräumen
Schimmelpilze sind natürlicher Bestandteil unserer Umwelt und verbreiten sich über die Luft. In Innenräumen entsteht Schimmelwachstum meist durch zu hohe Luftfeuchtigkeit oder bauliche Mängel. Die häufigsten Ursachen sind Feuchtigkeitsschäden, unzureichende Belüftung oder Temperaturunterschiede innerhalb von Räumen.
Rohrbrüche und bauliche Schäden
Bleibt Feuchtigkeit über längere Zeit im Mauerwerk bestehen, entstehen ideale Bedingungen für das Wachstum von Schimmelpilzen.
Erhöhte Luftfeuchtigkeit
Kondensation an kalten Wänden oder unzureichendes Lüften können zu Feuchtigkeitsansammlungen führen und Schimmelbildung begünstigen.
Häufige Fragen zur Schimmelpilzanalyse
Wann sollte eine Schimmelanalyse durchgeführt werden?
Eine Analyse ist sinnvoll, wenn sichtbarer Schimmelbefall vorliegt oder ein Verdacht auf versteckte Feuchtigkeitsschäden besteht. Auch bei gesundheitlichen Beschwerden kann eine Untersuchung hilfreich sein. So lassen sich Ursachen und Risiken frühzeitig erkennen.
Wie wird eine Schimmelprobe entnommen?
Die Proben werden gezielt an betroffenen Stellen entnommen, beispielsweise an Wänden, Tapeten oder anderen Materialien. Die Entnahme erfolgt fachgerecht, um aussagekräftige Ergebnisse zu erhalten. Anschließend wird die Probe im Labor analysiert.
Welche gesundheitlichen Risiken bestehen durch Schimmel?
Schimmel kann je nach Art und Belastung unterschiedliche Beschwerden auslösen, etwa Atemwegsprobleme oder allergische Reaktionen. Besonders empfindliche Personen reagieren oft stärker auf Schimmelpilze. Eine Analyse hilft, die Situation besser einzuschätzen.